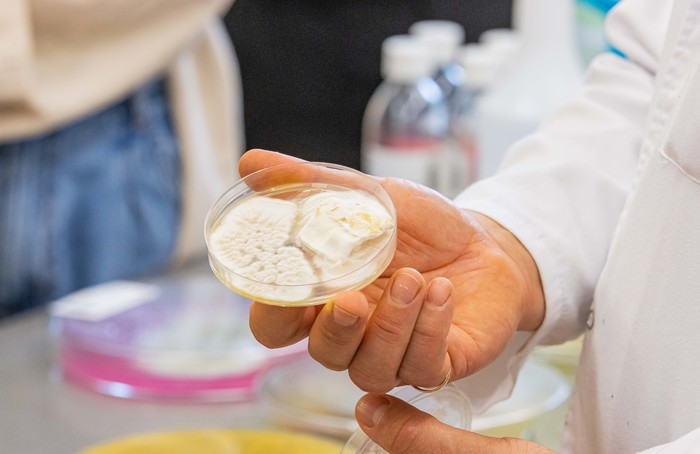

Histologia bez tajemnic
10.06.2022

Niemal 100 osób wzięło udział w Dniu Otwartym, który 9 czerwca br. zorganizowało Studenckie Koło Naukowe przy Katedrze i Zakładzie Histologii GUMed pod kierownictwem dr Grażyny Kotlarz. Podczas wydarzenia uczniowie gdańskich szkół wraz z opiekunami mieli okazję przekonać się, jak wygląda studiowanie.
W ramach Dnia Otwartego młodzież zwiedziła także Bibliotekę Główną i uniwersyteckie Muzeum. Dodatkowo pracownicy Działu Rekrutacji omówili proces rekrutacji na studia na wszystkie kierunki studiów, uwzględniając informacje dla laureatów i finalistów olimpiad, a Zakład Toksykologii Środowiska przygotował pokazy z zakresu badań ekotoksykologicznych na przykładzie rozwielitek (Daphnia magna) i artemii (Artemia fransiscana).
Wizytę w murach Gdańskiego Uniwersytetu Medycznego uczniowie Gdańskiego Liceum Autonomicznego, gdańskiego III LO i gdyńskiego VI LO rozpoczęli od Katedry i Zakładu Histologii, gdzie członkowie SKN Histologii pod opieką dr Grażyny Kotlarz zorganizowali prezentację preparatów histologicznych oglądanych pod mikroskopem świetlnym.

– Warsztaty poprzedzono wprowadzeniem o nauczaniu przedmiotu „Histologia z cytofizjologią” z wykorzystaniem cyfrowej histologii w czasie rzeczywistym. Na koniec spotkania uczestnicy mieli możliwość sprawdzenia swojej wiedzy, rozwiązując quiz z zakresu histologii – tłumaczyła dr Grażyna Kotlarz.
Zajęcia w Zakładzie Toksykologii Środowiska GUMed poprowadził dr Maciej Tankiewicz.
– Uczniowie mogli łowić organizmy wskaźnikowe, uruchamiać test oceny toksyczności ostrej i oceniać efekty pod mikroskopem. Zobaczyli, jak zbudowane są dafnie i jak wygląda ich cykl życia – wyjaśniał dr Tankiewicz. – Przybliżyliśmy im również, jak się ocenia wpływ zmian klimatu (w tym kwaśnych deszczy) na wzrost rzeżuchy.

W tracie warsztatów licealiści mogli samodzielnie sprawdzić poziom wysycenia swoich organizmów witaminą C oraz czystość dłoni. Dodatkowo poznali mikrobiologiczne zanieczyszczenia produktów spożywczych, zobaczyli, co tak naprawdę kryje się pod kolorowymi opakowaniami do żywności oraz dlaczego w świeżej i przetworzonej żywności używane są konserwanty.
fot. Paweł Sudara/GUMed
Archiwum
- Rok akademicki 2024/2025
- Rok akademicki 2023/2024
- Rok akademicki 2022/2023
- Rok akademicki 2021/2022
- Rok akademicki 2020/2021
- Rok akademicki 2019/2020
- Rok akademicki 2018/2019
- Rok akademicki 2017/2018
- Rok akademicki 2016/2017
- Rok akademicki 2015/2016
- Rok akademicki 2014/2015
- Rok akademicki 2013/2014
- Rok akademicki 2012/2013
- Rok akademicki 2011/2012
- Rok akademicki 2010/2011
- Rok akademicki 2009/2010
- Rok akademicki 2008/2009
- Rok akademicki 2007/2008
- Inauguracje roku akademickiego